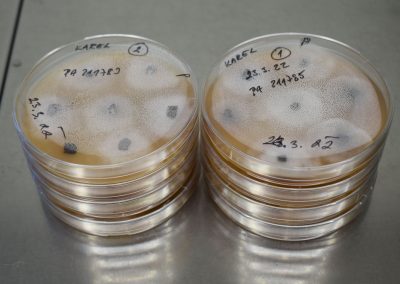

Českem se šíří plíseň olšová. Invazní patogen ohrožuje lužní a mokřadní olšiny
V důsledku globalizace obchodu s rostlinným materiálem a zavlékání nepůvodních druhů rostlin dochází v posledních letech k exponenciálnímu nárůstu invazních patogenů v naší přírodě. Některé z těchto patogenů jsou příčinou zásadních a často nevratných změn ekosystémů s environmentálními i ekonomickými dopady. Od konce 20. století se v České republice šíří plíseň olšová (Phytophthora alni), nebezpečný invazní patogen olší. Tým odborníků z Výzkumného ústavu pro krajinu (VÚK), České zemědělské univerzity v Praze a Univerzity Karlovy v novém výzkumu zanalyzoval její vliv na ekosystémy lužních a mokřadních lesů.
Výsledky ukázaly, že plíseň olšová je nebezpečnější než v minulosti. Nejinfekčnější a nejzhoubnější genotyp je více rozšířen a dostal se i na lokality, kde dříve dominovaly méně agresivní kmeny patogenu. „Očekávali jsme, že v celkově početně slabší populaci hostitele budou spíš přežívat genotypy s nižší virulencí. Bohužel je to naopak, což znamená, že lokální přežívající/dosud nezasažené populace budou v budoucnu napadeny nejvíce patogenním genotypem – budou v nich způsobeny velké škody,“ říká vedoucí Odboru biologických rizik VÚK Karel Černý.
Přestože je plíseň olšová závažným patogenem a její patogenita neklesá, má na změnách biodiverzity a obecně fungování lužních a mokřadních lesů jen omezený podíl. Lužní a mokřadní lesy jsou zasaženy spíše mozaikovitě a velmi zřídka byl zaznamenán úplný rozpad stromového patra (prakticky pouze v mokřadních olšinách). „V lesích se toho stalo za poslední dvě dekády mnoho a většinou se druhová diverzita rostlin snížila, zodpovědné jsou za to ale spíše sukcesní změny, změny klimatu a eutrofizace. Plíseň olšová zapříčinila jen malou část změn biodiverzity a v některých případech dokonce přispěla k obnově druhově bohatých mokřadů,“ vysvětluje Jaroslav Vojta z Odboru prostorové ekologie VÚK.
Plíseň olšová je v území limitována v podstatě pouze klimatickými faktory. Významnější rozšiřování areálu v území lze proto podobně jako u dalších patogenů očekávat s postupující změnou klimatu. Vývoj v lužních a mokřadních společenstvech bude dále předmětem dlouhodobého sledování. „Plánujeme dlouhodobý monitoring změn v postižených společenstvech olšin a pokračování rezistentního šlechtění. Zároveň plánujeme podobný výzkum u dalších patogenů,“ dodává Černý.
Projekt s názvem Identifikace rizikových změn struktury a diverzity mokřadních olšin a olšových luhů v důsledku invaze plísně olšové (Phytophthora alni) a stanovení perspektivy vývoje společenstev byl podpořen Technologickou agenturou ČR. Kompletní výsledky projektu jsou k dispozici na stránce projektu ZDE.
Kontakt pro média:
Mgr. Jaroslav Vojta, Ph.D.
hlavní řešitel projektu za VÚK
Odbor prostorové ekologie
Telefon: 296 528 274
Email: vojta@vukoz.cz